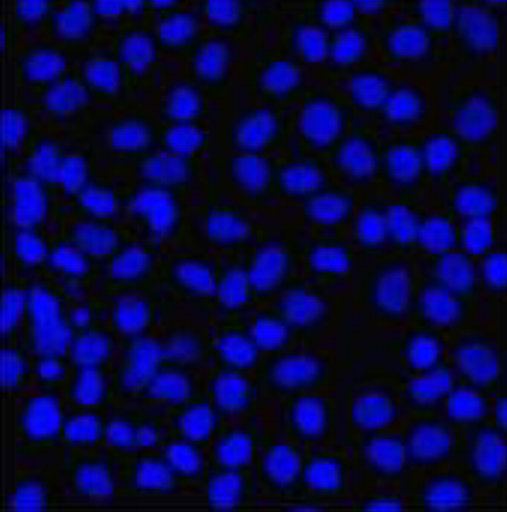
上海细胞DAPI染色实验

万千商家帮你免费找货
0 人在求购买到急需产品
- 详细信息
- 技术资料
- 提供商:
上海达为科生物科技有限公司
- 服务名称:
细胞DAPI染色实验
一、DAPI染色的基本原理
-
分子作用机制
DAPI通过嵌入DNA双螺旋的小沟区,与AT碱基对形成氢键和π-π堆积作用,结合后荧光强度增强约20倍。其激发波长为358-360 nm,发射波长为460-461 nm,呈现蓝色荧光。尽管DAPI也可与RNA结合(AU序列),但其荧光量子产率仅为DNA结合的20%,且发射波长偏移至500 nm,因此主要作为DNA特异性探针。 -
染色特异性与优势
- 高DNA选择性:对细胞核染色专一性强,细胞质背景信号低。
- 多场景适用:兼容固定细胞和活细胞(需高浓度),适用于荧光显微镜、流式细胞术、染色体分析等。
- 荧光稳定性:光稳定性优于Hoechst染料,抗淬灭能力较强。
二、实验操作流程
1. 固定与透化处理
- 固定:常用3.7%甲醛固定10分钟,以维持细胞核形态并固定DNA。
- 透化:0.2% Triton X-100处理5分钟,增加细胞膜通透性,促进DAPI进入。
2. DAPI染色步骤
- 稀释工作液:将原液按1:5000比例用PBS稀释至终浓度0.1-1 μg/mL。
- 孵育时间:室温避光染色1-5分钟,活细胞需延长至10-20分钟。
- 清洗与成像:PBS冲洗3次,封片后立即观察以避免荧光衰减。
3. 多色荧光兼容性
DAPI的蓝色荧光与绿色(如FITC)、红色(如Texas Red)染料发射波长重叠较少,适合多重染色实验。
三、试剂配制与储存
| 试剂 | 配制方法 | 储存条件 |
|---|---|---|
| DAPI储备液(5 mg/mL) | 1 mg DAPI粉末溶于200 μL去离子水或DMF(需超声助溶) | 避光,-20℃长期保存 |
| DAPI工作液(300 nM) | 取14.3 mM储备液2.1 μL加入100 μL PBS,再稀释至1:1000 | 现用现配,4℃短期保存 |
| PBS缓冲液(pH 7.0) | 0.1 M NaH2PO4·H2O 34 mL + 0.1 M Na2HPO4 66 mL + NaCl 0.9 g,定容至1 L | 4℃保存,避免污染 |
四、关键注意事项
- 安全防护:DAPI具有潜在诱变性,操作时需戴手套并避免直接接触。
- 荧光淬灭:染色后应尽快检测(推荐当天完成),使用抗淬灭封片剂可延长信号持续时间。
- 背景控制:避免过度染色,稀释液需精确配制;透化时间过长可能导致核结构破坏。
- 活细胞染色:DAPI对活细胞膜穿透性有限,需提高浓度(10 μg/mL)或延长孵育时间。
风险提示:丁香通仅作为第三方平台,为商家信息发布提供平台空间。用户咨询产品时请注意保护个人信息及财产安全,合理判断,谨慎选购商品,商家和用户对交易行为负责。对于医疗器械类产品,请先查证核实企业经营资质和医疗器械产品注册证情况。
技术资料暂无技术资料 索取技术资料
上海细胞DAPI染色实验
询价









